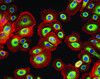
Fabienne Guyard, BIOalternatives, France

Low-antigen-content diet in the treatment of patients with mixed cryoglobulinemia
Article Abstract:
Mixed cryoglobulinemia (MC) is a systemic disease characterized by excessive quantities of cryoglobulins (abnormal proteins in the blood), which are formed by certain rheumatoid factors and immunoglobulins (antibodies) in the blood or in the lymphatic system. Cryoglobulins have a toxic effect on the body. Among the symptoms of this condition are purpura (formation of purple spots on the skin and mucous membranes), weakness and arthralgias (joint pain). The authors describe their experience in treating 24 MC patients with a low antigen content (LAC) diet. This diet eliminates meat (except turkey), eggs and dairy products, food additives and preservatives and all beverages except water. The diet is rich in fruits and vegetables. One group of patients was put on the LAC diet for 18 weeks, while a control group was placed on an unrestricted diet. Both groups were then placed on an unrestricted diet for 12 weeks. The LAC group was then continued on the unrestricted diet and the unrestricted group was placed on the LAC diet for 18 weeks. While following the LAC diet, the patients showed a reduction in the levels of immunoglobulins and rheumatoid factors responsible for MC. No significant change occurred while the patients were on the unrestricted normal diet. Several symptoms of MC, particularly purpura and liver damage, improved following the LAC diet. Although the authors are not prepared to conclude that these improvements were directly attributable to the LAC diet, they report that the LAC diet is a safe therapeutic method for reducing the factors that contribute to MC.
Publication Name: American Journal of Medicine
Subject: Health care industry
ISSN: 0002-9343
Year: 1989
User Contributions:
Comment about this article or add new information about this topic:
Mixed cryoglobulinemia responsive to interferon-alpha
Article Abstract:
Cryoglobulinemia is characterized by an abnormal protein in the blood, and may accompany a number of different disorders. Type II cryoglobulinemia is associated with hepatitis. Blood filtration can reduce levels of the protein and diminish kidney and nerve complications, but the proteins may often re-accumulate. A 38-year-old patient is described with chronic hepatitis C, cirrhosis, and mixed cryoglobulinemia, who improved when treated with low doses of interferon (IFN). She had developed jaundice after a blood transfusion in 1978, which had progressed to chronic active hepatitis that was not responsive to steroid therapy. After 10 years, she developed a headache and rash over the abdomen and legs. Several tests of blood proteins were abnormal. The rash and headache resolved after blood filtration, but cryoglobulinemia then recurred. Hypertension and protein in urine, both signs of kidney dysfunction, developed. Continued progression of the disorder prompted a trial with IFN. Although chronic fatigue, ankle edema (fluid accumulation), and liver function tests did not improve, cryoglobulin levels decreased five-fold with treatment. When IFN was discontinued, cryoglobulinemia and the rash recurred. This report indicates that IFN-alpha is effective in treating at least some cases of cryoglobulinemia; it is also less costly and less hazardous than frequent blood filtration. Further research to substantiate these results and to optimize the treatment protocol is needed. (Consumer Summary produced by Reliance Medical Information, Inc.)
Publication Name: American Journal of Medicine
Subject: Health care industry
ISSN: 0002-9343
Year: 1991
User Contributions:
Comment about this article or add new information about this topic:
Mixed essential cryoglobulinemia and adult respiratory distress syndrome: a case report
Article Abstract:
Cryoglobulinemia is the presence of an abnormal immunoglobulin protein in the blood that forms a gel at low temperatures and dissolves on rewarming. Vasculitis, inflammation of small blood vessels, often occurs with cryoglobulinemia. The skin, kidneys and nervous system can also be affected by this disorder. Lung involvement seems to be rare. This case report describes a 38-year-old woman who is diagnosed with cryoglobulinemia and adult respiratory distress syndrome (ARDS) after being admitted to the hospital with a long history of Raynaud's disease (abnormal constriction of blood vessels in the extremities upon exposure to cold) and purpura (hemorrhages into the skin) and a one-week history of fever, chills, weakness, joint pain and cough. On examination the patient had a fever, enlarged liver and spleen, skin hemorrhages and areas of discoloration; chest x-ray indicated pneumonia. Several days after beginning antibiotic therapy the patient's fever rose and she sustained respiratory failure; she was placed on a respirator and ARDS was diagnosed. Discoloration of her fingers then progressed to necrotic gangrene (tissue death). Factors which usually lead to the development of ARDS are sepsis, trauma, aspiration and shock; none of these events occurred in this patient. The development of ARDS may have been related to the same pathologic mechanisms that cause small blood vessel damage in cryoglobulinemia; the abnormal immunoglobulin may directly or indirectly cause ARDS.
Publication Name: American Journal of Medicine
Subject: Health care industry
ISSN: 0002-9343
Year: 1989
User Contributions:
Comment about this article or add new information about this topic:
- Abstracts: Ambulatory antibiotic infusion devices: extending the spectrum of outpatient therapies. Common symptoms in ambulatory care: incidence, evaluation, therapy, and outcome
- Abstracts: Prevalence and clinical characteristics of a high cardiac output state in patients with multiple myeloma. Complement abnormalities in multiple myeloma